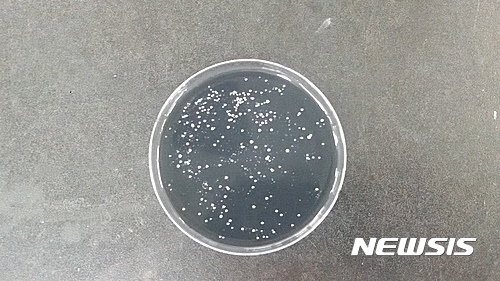
【대구=뉴시스】레지오넬라균 집락(集落)이 형성된 모습. 뉴시스DB. 2025.05.26.&nbsp; photo@newsis.com

【대구=뉴시스】레지오넬라균 집락(集落)이 형성된 모습. 뉴시스DB. 2025.05.26. [email protected]
[대구=뉴시스] 정창오 기자 = 대구시 보건환경연구원은 여름철을 맞아 레지오넬라증 예방과 관리를 위해 다중이용시설을 대상으로 레지오넬라균을 검사한다고 26일 밝혔다.
이번 검사는 6월부터 종합병원, 요양병원, 숙박시설, 대형건물, 백화점 및 쇼핑센터 등의 냉각탑, 급수시설을 대상으로 진행되며 7월부터 9월까지는 냉각탑수와 분수대를 집중적으로 검사한다.
레지오넬라증은 오염된 냉각탑수, 대중목욕탕의 욕조수, 샤워기, 수도꼭지 등의 물속에 존재하는 레지오넬라균이 비말 형태로 인체에 흡입되면서 감염되는 호흡기질환이다.
증상은 독감이나 폐렴과 유사하며, 대부분 산발적으로 발생하지만, 여름철과 초가을에는 집단발생 위험이 커 각별한 주의가 필요하다.
보건환경연구원이 지난해 냉각탑과 급수시설 등 총 665건을 검사한 결과 9건에서 레지오넬라균이 검출돼 해당 시설에 대한 소독과 재검사 등 필요한 조치가 이뤄졌다.
신상희 대구시 보건환경연구원장은 “다중이용시설을 통한 레지오넬라증 집단감염 예방을 위해 철저한 검사를 지속해 나갈 것"이라며 “시민께서도 가정 내 샤워기, 수도꼭지 등을 주기적으로 청소하는 등 예방에 적극 동참해 주시길 바란다”고 당부했다.
◎공감언론 뉴시스 [email protected]
